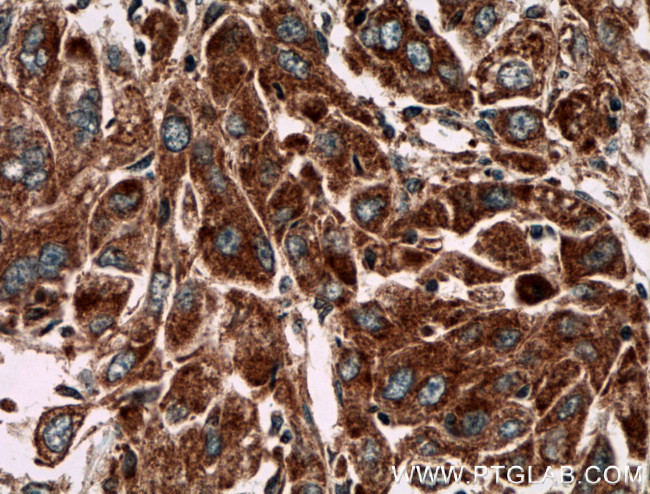
PIP5K1C Antibody in Immunohistochemistry (Paraffin) (IHC (P))

Search
Proteintech
PIP5K1C Polyclonal Antibody
{{$productOrderCtrl.translations['antibody.pdp.commerceCard.promotion.promotions']}}
{{$productOrderCtrl.translations['antibody.pdp.commerceCard.promotion.viewpromo']}}
{{$productOrderCtrl.translations['antibody.pdp.commerceCard.promotion.promocode']}}: {{promo.promoCode}} {{promo.promoTitle}} {{promo.promoDescription}}. {{$productOrderCtrl.translations['antibody.pdp.commerceCard.promotion.learnmore']}}
产品信息
27640-1-AP
种属反应
宿主/亚型
分类
类型
抗原
偶联物
形式
浓度
规格
纯化类型
保存液
内含物
保存条件
运输条件
产品详细信息
Immunogen sequence: MIPSEREEA QYDLRGARSY PTLEDEGRPD LLPCTPPSFE EATTASIATT LSSTSLSIPE RSPSETSEQP RYRRRTQSSG QDGRPQEEPP AEEDLQ (480-573 aa encoded by NM_001195733)
靶标信息
PIP5K1C lipid kinase or phosphatidylinositol-4-phosphate 5-kinase 1 gamma phosphorylates phosphatidylinositol-4-phosphate to form phosphatidylinositol 4,5-bisphosphate. PIP5K1C is found at synapses and has been found to play roles in endocytosis and cell migration. PIP5K1C directly associates with -beta-catenin and increases -beta-catenin activity downstream of growth factor stimulation. PIP5K1C expression and kinase activity enhance -beta-catenin phosphorylation on residues that promote nuclear importation and transcriptional activity. PIP5K1C deficiency impairs neutrophil recruitment as a result of defect in adhesion. PIP5K1C regulated the adhesion through facilitation of RhoA GTPase and integrin activation by chemo attractants.
仅用于科研。不用于诊断过程。未经明确授权不得转售。
生物信息学
蛋白别名: diphosphoinositide kinase; Phosphatidylinositol 4-phosphate 5-kinase type-1 gamma; phosphatidylinositol-4-phosphate 5-kinase; phosphatidylinositol-4-phosphate 5-kinase, type I, gamma; phosphoinositide 5-kinase; PIP5K1gamma; PIP5KI gamma; PIP5KI-gamma; PIPKIg_v4; ptdIns(4)P-5-kinase 1 gamma; Type I phosphatidylinositol 4-phosphate 5-kinase gamma; type I PIP kinase; unnamed protein product
基因别名: KIAA0589; LCCS3; PIP5K-GAMMA; PIP5K1-gamma; PIP5K1C; PIP5Kgamma
UniProt ID: (Human) O60331
Entrez Gene ID: (Human) 23396